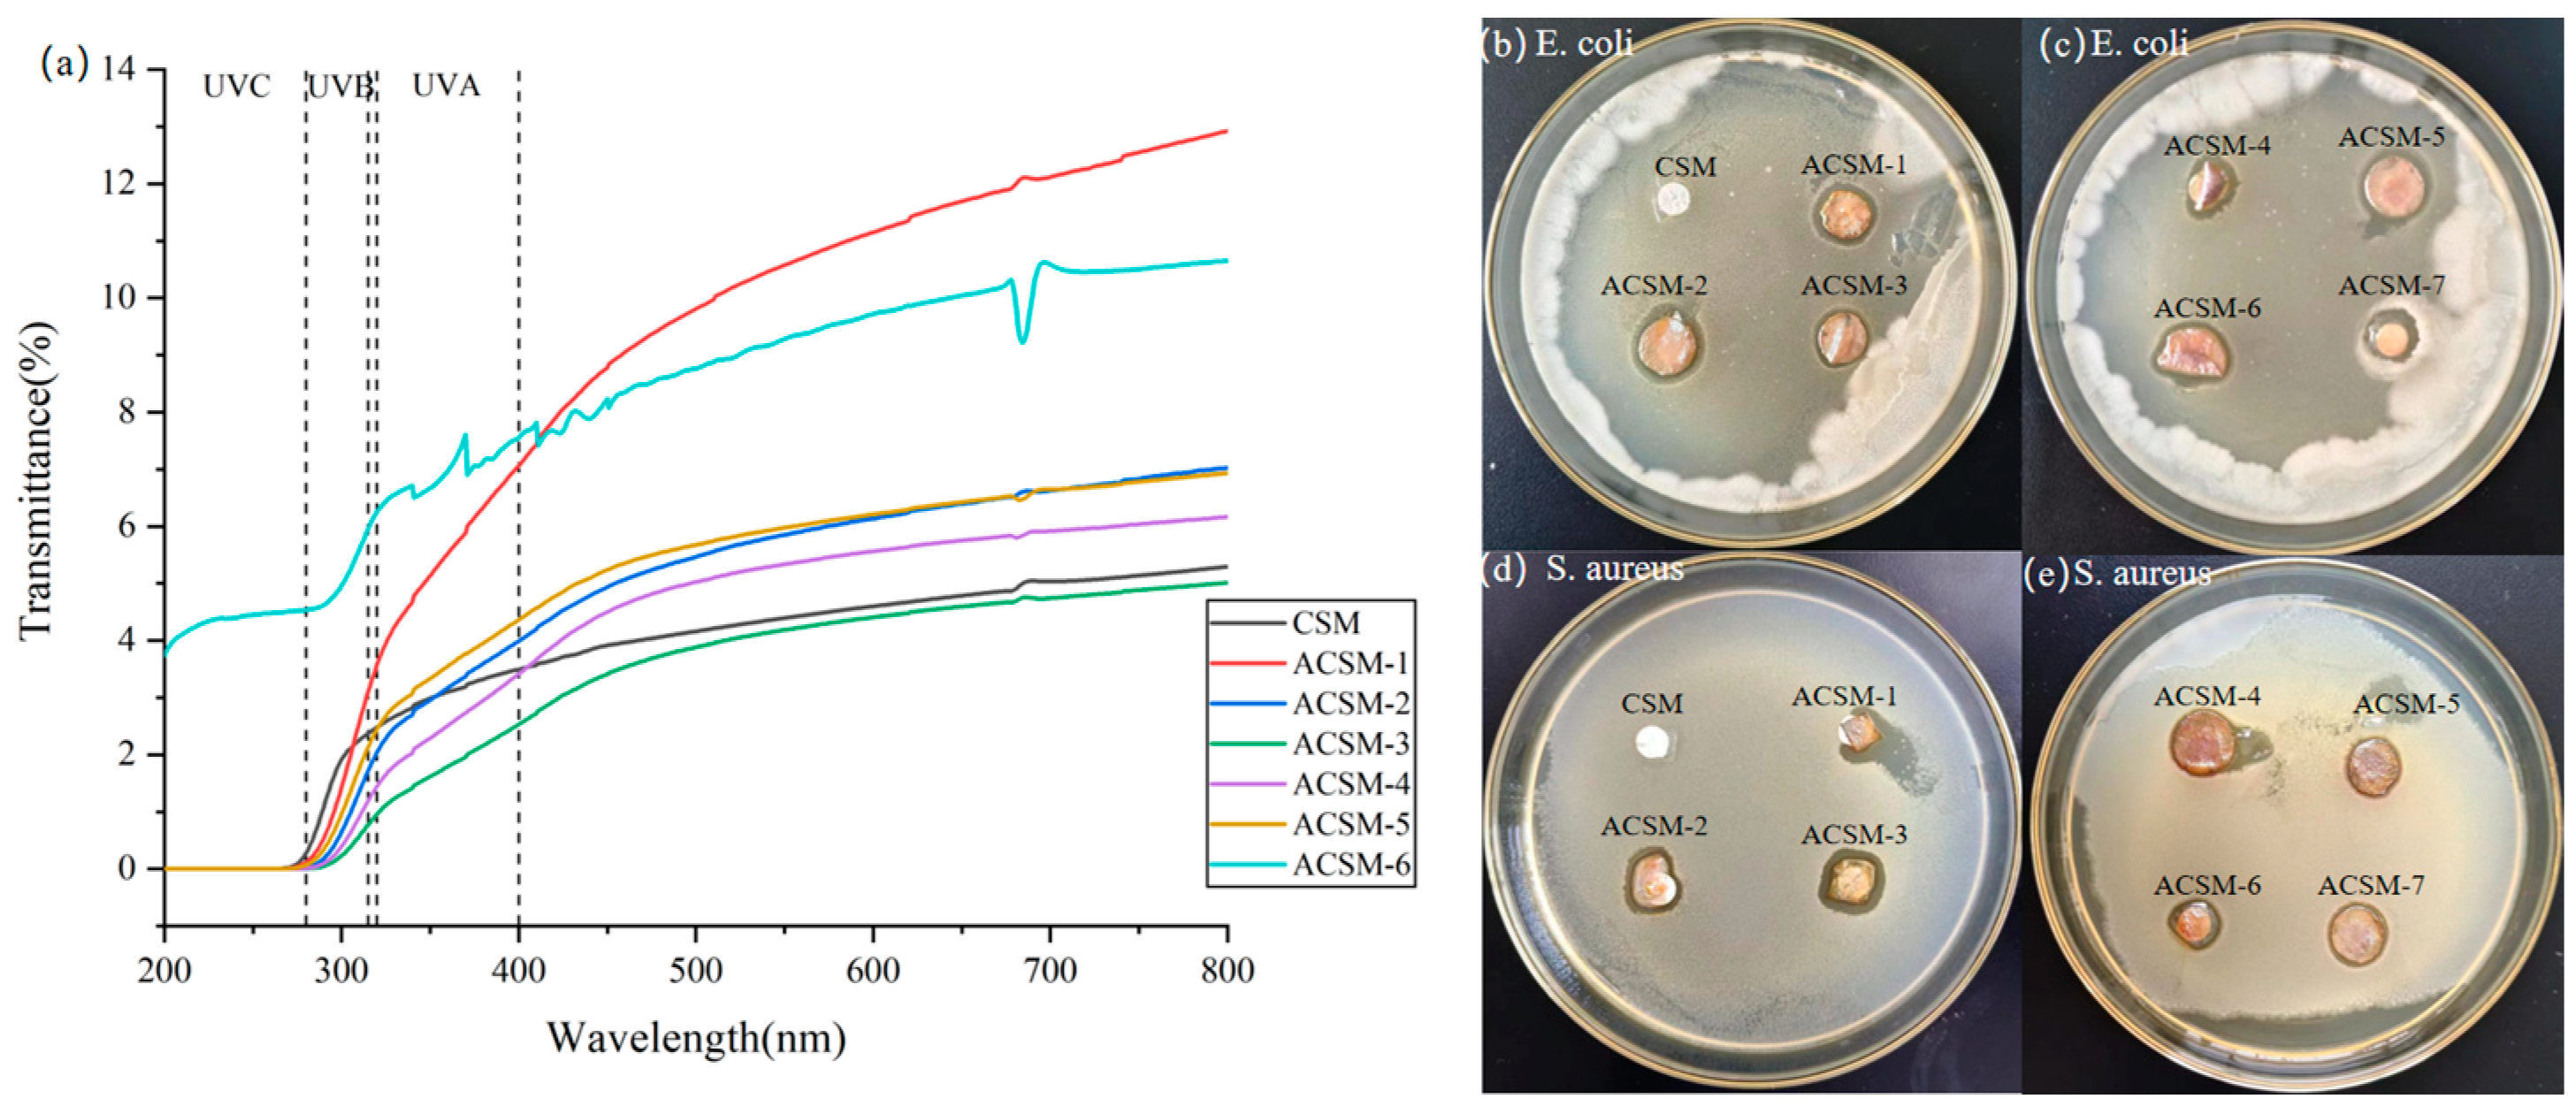
Polymers 16 01282 g008

Antimicrobial Properties of Carboxymethyl Cellulose/Starch/N’N Methylenebisacrylamide Membranes Endowed by Ultrasound and Their Potential Application in Antimicrobial Packaging
Abstract
1. Introduction
2. Materials and Methods
2.1. Materials
2.2. Preparation of Carboxymethyl Cellulose-Based Films
2.3. Sonication Treatment of Carboxymethyl Cellulose-Based Films
2.4. Characterization
2.5. Antibacterial Performance Test
3. Results and Discussion
3.1. Morphology of ACSM Composite Films
3.2. ACSM Composite Membranes Structure and Components
3.3. Thermal Stability and Hydrophobicity of ACSM Composite Membranes
3.4. Light Transmission Analysis and Antimicrobial Properties of ACSM Composite Membranes
4. Conclusions
Author Contributions
Funding
Institutional Review Board Statement
Informed Consent Statement
Data Availability Statement
Acknowledgments
Conflicts of Interest
References
- Mostafa, Y.S.; Alrumman, S.A.; Alamri, S.A.; Otaif, K.A.; Mostafa, M.S.; Alfaify, A.M. Bioplastic (poly-3-hydroxybutyrate) production by the marine bacterium Pseudodonghicola xiamenensis through date syrup valorization and structural assessment of the biopolymer. Sci. Rep. 2020, 10, 8815. [Google Scholar] [CrossRef]
- Zhang, W.; Ji, X.-X.; Ma, M.-G. Emerging MXene/cellulose composites: Design strategies and diverse applications. Chem. Eng. J. 2023, 458, 141402. [Google Scholar] [CrossRef]
- Wang, X.; Tarahomi, M.; Sheibani, R.; Xia, C.; Wang, W. Progresses in lignin, cellulose, starch, chitosan, chitin, alginate, and gum/carbon nanotube (nano)composites for environmental applications: A review. Int. J. Biol. Macromol. 2023, 241, 124472. [Google Scholar] [CrossRef]
- Lin, H.; Ma, M.; Chu, Q.; Xu, L.; Chen, S.; Shi, Y.; He, H.; Wang, X. Multifunctional nanofibrillated cellulose/ZnO@rGO composite films for thermal conductivity, electrical insulation, and antibacterial applications. Compos. Struct. 2023, 312, 116896. [Google Scholar] [CrossRef]
- Santana, R.M.d.R.; Napoleão, D.C.; Rodriguez-Diaz, J.M.; Gomes, R.K.d.M.; Silva, M.G.; Garcia, R.R.P.; Vinhas, G.M.; Duarte, M.M.M.B. Original nanostructured bacterial cellulose/pyrite composite: Photocatalytic application in advanced oxidation processes. Chemosphere 2023, 319, 137953. [Google Scholar] [CrossRef]
- Ren, H.; Xu, Z.; Gao, M.; Xing, X.; Ling, Z.; Pan, L.; Tian, Y.; Zheng, Y.; Fan, W.; Yang, W. Preparation of microcrystalline cellulose from agricultural residues and their application as polylactic acid/microcrystalline cellulose composite films for the preservation of Lanzhou lily. Int. J. Biol. Macromol. 2023, 227, 827–838. [Google Scholar] [CrossRef]
- Musarurwa, H.; Tavengwa, N.T. Cellulose composites tethered with smartness and their application during wastewater remediation. React. Funct. Polym. 2022, 178, 105332. [Google Scholar] [CrossRef]
- Meng, S.; Wu, H.; Xiao, D.; Lan, S.; Dong, A. Recent advances in bacterial cellulose-based antibacterial composites for infected wound therapy. Carbohydr. Polym. 2023, 316, 121082. [Google Scholar] [CrossRef] [PubMed]
- Orsuwan, A. Effect of cellulose nanocrystals and green synthesized silver nanoparticles on mechanical properties and antimicrobial activity of banana flour/agar composite films. Heliyon 2023, 9, e15102. [Google Scholar] [CrossRef]
- Jabbarvand Behrouz, S.; Khataee, A.; Safarpour, M.; Arefi-Oskoui, S.; Woo Joo, S. Carboxymethyl cellulose/polyethersulfone thin-film composite membranes for low-pressure desalination. Sep. Purif. Technol. 2021, 269, 118720. [Google Scholar] [CrossRef]
- Sabarish, R.; Unnikrishnan, G. Polyvinyl alcohol/carboxymethyl cellulose/ZSM-5 zeolite biocomposite membranes for dye adsorption applications. Carbohydr. Polym. 2018, 199, 129–140. [Google Scholar] [CrossRef] [PubMed]
- Techavuthiporn, C.; Nimitkeatkai, H.; Thammawong, M.; Nakano, K. A coating made from carboxymethyl cellulose derived from commercial nata de coco reduces postharvest changes in ‘Hom Thong’ banana fruit during ambient storage. Postharvest Biol. Technol. 2024, 208, 112650. [Google Scholar] [CrossRef]
- Chen, J.; Qin, T.; Cheng, Y.; Fang, C.; Zhang, X.; Chen, M. Surface charge regulation of imidazolium salts/starch/carboxymethyl cellulose ternary polymer blend films for controlling antimicrobial performance and hydrophobicity. Int. J. Biol. Macromol. 2023, 245, 125519. [Google Scholar] [CrossRef] [PubMed]
- Hu, Q.; Huang, Z.; Zhang, H.; Ma, P.; Feng, R.; Feng, J. Coaxial electrospun Ag-NPs-loaded endograft membrane with long-term antibacterial function treating mycotic aortic aneurysm. Mater. Today Bio 2024, 25, 100940. [Google Scholar] [CrossRef] [PubMed]
- Saravanakumar, K.; Li, Z.; Kim, Y.; Park, S.; Keon, K.; Lee, C.-M.; Ahn, G.; Cho, N. Fucoidan-coated cotton dressing functionalized with biomolecules capped silver nanoparticles (LB-Ag nps–FN–ocg) for rapid healing therapy of infected wounds. Environ. Res. 2023, 246, 118004. [Google Scholar] [CrossRef] [PubMed]
- Alharbi, N.S.; Khaled, J.M.; Alanazi, K.; Kadaikunnan, S.; Alobaidi, A.S. Biosynthesis of silver nanoparticles (Ag-NPs) using Senna alexandrina grown in Saudi Arabia and their bioactivity against multidrug-resistant pathogens and cancer cells. Saudi Pharm. J. 2023, 31, 911–920. [Google Scholar] [CrossRef] [PubMed]
- Perelshtein, I.; Perkas, N.; Gedanken, A. The Sonochemical Coating of Textiles with Antibacterial Nanoparticles. In Handbook of Antimicrobial Coatings; Elsevier: Amsterdam, The Netherlands, 2018; pp. 235–255. [Google Scholar] [CrossRef]
- Manickam, S.; Camilla Boffito, D.; Flores, E.M.M.; Leveque, J.-M.; Pflieger, R.; Pollet, B.G.; Ashokkumar, M. Ultrasonics and sonochemistry: Editors’ perspective. Ultrason. Sonochem. 2023, 99, 106540. [Google Scholar] [CrossRef] [PubMed]
- Bai, M.; Dai, J.; Li, C.; Cui, H.; Lin, L. Antibacterial and antibiofilm performance of low-frequency ultrasound against Escherichia coli O157:H7 and its application in fresh produce. Int. J. Food Microbiol. 2023, 400, 110266. [Google Scholar] [CrossRef]
- Dursun Capar, T. Characterization of sodium alginate-based biodegradable edible film incorporated with Vitis vinifera leaf extract: Nano-scaled by ultrasound-assisted technology. Food Packag. Shelf Life 2023, 37, 101068. [Google Scholar] [CrossRef]
- Li, W.; You, Q.; Zhang, J.; Li, W.; Xu, H. Green synthesis of antibacterial LFL-ZnO using L. plantarum fermentation liquid assisted by ultrasound-microwave. J. Alloys Compd. 2023, 947, 169697. [Google Scholar] [CrossRef]
- Liang, M.; Shang, L.; Yu, Y.; Jiang, Y.; Bai, Q.; Ma, J.; Yang, D.; Sui, N.; Zhu, Z. Ultrasound activatable microneedles for bilaterally augmented sono-chemodynamic and sonothermal antibacterial therapy. Acta Biomater. 2023, 158, 811–826. [Google Scholar] [CrossRef] [PubMed]
- Muruganandham, M.; Sivasubramanian, K.; Velmurugan, P.; Suresh Kumar, S.; Arumugam, N.; Almansour, A.I.; Suresh Kumar, R.; Manickam, S.; Pang, C.H.; Sivakumar, S. An eco-friendly ultrasound approach to extracting yellow dye from Cassia alata flower petals: Characterization, dyeing, and antibacterial properties. Ultrason. Sonochem. 2023, 98, 106519. [Google Scholar] [CrossRef] [PubMed]
- Qi, F.; Li, Z.; Li, H.; Chen, G.; Luo, X.; Xiong, S.; Peng, S.; Zhu, H.; Shuai, C. An ultrasound-activated heterojunction as ROS generator given scaffolds sonodynamic antibacterial effect. Vacuum 2023, 216, 112433. [Google Scholar] [CrossRef]
- Qu, W.; Xiong, T.; Wang, B.; Li, Y.; Zhang, X. The modification of pomegranate polyphenol with ultrasound improves mechanical, antioxidant, and antibacterial properties of tuna skin collagen-chitosan film. Ultrason. Sonochem. 2022, 85, 105992. [Google Scholar] [CrossRef]
- Yang, H.; Zhan, X.; Song, L.; Cheng, S.; Su, R.; Zhang, Y.; Guo, D.; Lü, X.; Xia, X.; Shi, C. Synergistic antibacterial and anti-biofilm mechanisms of ultrasound combined with citral nanoemulsion against Staphylococcus aureus 29213. Int. J. Food Microbiol. 2023, 391–393, 110150. [Google Scholar] [CrossRef] [PubMed]
- Zalipour, Z.; Lashanizadegan, A.; Sadeghfar, F.; Ghaedi, M.; Asfaram, A.; Sadegh, F. Electrochemical synthesis of CNTs–Zn: ZnO@SDS/PEG@Ni2P nanocomposite and its application for ultrasound-assisted removal of methylene blue and investigation of its antibacterial property. Environ. Nanotechnol. Monit. Manag. 2022, 18, 100721. [Google Scholar] [CrossRef]
- Zhai, X.; Liu, N.; Ju, P.; Jiang, Q.; Liu, X.; Guan, F.; Ren, Y.; Duan, J.; Hou, B. Novel BiPO4-Zn electrodeposited coatings with highly enhanced photocatalytic antibacterial activities controlled by ultrasound and EDTA-2Na. J. Alloys Compd. 2023, 937, 168338. [Google Scholar] [CrossRef]
- Wang, W.; Yu, Z.; Alsammarraie, F.K.; Kong, F.; Lin, M.; Mustapha, A. Properties and antimicrobial activity of polyvinyl alcohol-modified bacterial nanocellulose packaging films incorporated with silver nanoparticles. Food Hydrocoll. 2020, 100, 105411. [Google Scholar] [CrossRef]
- Sarojini, S.; Vanathi Vijayalakshmi, R. XPS studies on silver ion conducting solid electrolyte SbI3-Ag2MoO4. Mater. Today Proc. 2022, 68, 314–318. [Google Scholar] [CrossRef]
- Han, C.H.; Min, B.G. Superhydrophobic and Antibacterial Properties of Cotton Fabrics Coated with Copper Nanoparticles through Sonochemical Process. Fibers Polym. 2020, 21, 785–791. [Google Scholar] [CrossRef]
- Ding, Y.; Yu, W.; Zhang, J.; Liu, W.; Zhu, F.; Ye, Y.; Zheng, Q. Enhanced antibacterial properties of poly(butylene succinate-co-terephthalate)/Ag@MgO nanocomposite films for food packaging. Polym. Test. 2023, 128, 108230. [Google Scholar] [CrossRef]
- Chien, C.-S.; Lin, C.-J.; Ko, C.-J.; Tseng, S.-P.; Shih, C.-J. Antibacterial activity of silver nanoparticles (AgNP) confined to mesostructured silica against methicillin-resistant Staphylococcus aureus (MRSA). J. Alloys Compd. 2018, 747, 1–7. [Google Scholar] [CrossRef]

| Sample Number | Reducer EG Content/g | Sonication Time/min |
|---|---|---|
| CSM | 0 | 0 |
| ACSM-1 | 10 | 15 |
| ACSM-2 | 10 | 30 |
| ACSM-3 | 10 | 45 |
| ACSM-4 | 10 | 60 |
| ACSM-5 | 8.5 | 45 |
| ACSM-6 | 7 | 45 |
| ACSM-7 | 10 | 0 |
| Sample Number | Weight Loss between 30–260 °C/% | Weight Loss between 260–350 °C/% | Tp/°C | Weight Loss Rate at Tp/(%/t) |
|---|---|---|---|---|
| ACSM-1 | 67.76 | 16.42 | 130 | 10.72 |
| ACSM-2 | 46.40 | 26.50 | 124 | 5.73 |
| ACSM-3 | 47.06 | 22.87 | 125 | 6.74 |
| ACSM-4 | 51.06 | 17.49 | 129 | 8.39 |
| ACSM-5 | 51.52 | 24.66 | 121 | 6.85 |
| ACSM-6 | 49.60 | 24.14 | 120 | 7.19 |
| Sample Number | Peak 1 | Peak 2 | ||||||
|---|---|---|---|---|---|---|---|---|
| Tonset/°C | Tendset/°C | Δ H/(J/g) | Peak T/°C | Tonset/°C | Tendset/°C | Δ H/(J/g) | Peak T/°C | |
| CSM | 39.4 | 203.1 | 75.6 | 129 | 243.3 | 304.7 | 36.2 | 278 |
| ACSM-1 | 36.7 | 149.6 | 70.9 | 116 | 150.5 | 223.4 | 73.0 | 192 |
| ACSM-2 | 34.8 | 153.3 | 59.1 | 130 | 157.4 | 261.1 | 60.5 | 197 |
| ACSM-3 | 37.6 | 152.8 | 58.0 | 119 | 150.9 | 229.0 | 53.1 | 192 |
| ACSM-4 | 37.2 | 158.9 | 53.6 | 133 | 158.9 | 243.5 | 62.0 | 200 |
| ACSM-5 | 37.1 | 154.2 | 59.7 | 124 | 154.7 | 279.2 | 65.4 | 194 |
| ACSM-6 | 38.1 | 158.9 | 58.4 | 128 | 159.3 | 250.9 | 55.8 | 197 |
| Sample Number | T at 315 nm/% | T at 400 nm/% | T at 400 nm/% |
|---|---|---|---|
| CSM | 2.37 | 3.49 | 5.04 |
| ACSM-1 | 3.10 | 7.06 | 12.12 |
| ACSM-2 | 1.72 | 3.99 | 6.63 |
| ACSM-3 | 0.77 | 2.53 | 4.74 |
| ACSM-4 | 1.19 | 3.41 | 5.92 |
| ACSM-5 | 2.13 | 4.36 | 6.65 |
| ACSM-6 | 5.95 | 7.55 | 10.59 |
Disclaimer/Publisher’s Note: The statements, opinions and data contained in all publications are solely those of the individual author(s) and contributor(s) and not of MDPI and/or the editor(s). MDPI and/or the editor(s) disclaim responsibility for any injury to people or property resulting from any ideas, methods, instructions or products referred to in the content. |
© 2024 by the authors. Licensee MDPI, Basel, Switzerland. This article is an open access article distributed under the terms and conditions of the Creative Commons Attribution (CC BY) license (https://creativecommons.org/licenses/by/4.0/).
Share and Cite
Cheng, Y.; Cheng, X.; Fang, C.; Chen, J.; Zhang, X.; Cao, C.; Wang, J. Antimicrobial Properties of Carboxymethyl Cellulose/Starch/N’N Methylenebisacrylamide Membranes Endowed by Ultrasound and Their Potential Application in Antimicrobial Packaging. Polymers 2024, 16, 1282. https://doi.org/10.3390/polym16091282
Cheng Y, Cheng X, Fang C, Chen J, Zhang X, Cao C, Wang J. Antimicrobial Properties of Carboxymethyl Cellulose/Starch/N’N Methylenebisacrylamide Membranes Endowed by Ultrasound and Their Potential Application in Antimicrobial Packaging. Polymers. 2024; 16(9):1282. https://doi.org/10.3390/polym16091282
Chicago/Turabian StyleCheng, Youliang, Xinyi Cheng, Changqing Fang, Jing Chen, Xin Zhang, Changxue Cao, and Jinpeng Wang. 2024. "Antimicrobial Properties of Carboxymethyl Cellulose/Starch/N’N Methylenebisacrylamide Membranes Endowed by Ultrasound and Their Potential Application in Antimicrobial Packaging" Polymers 16, no. 9: 1282. https://doi.org/10.3390/polym16091282
APA StyleCheng, Y., Cheng, X., Fang, C., Chen, J., Zhang, X., Cao, C., & Wang, J. (2024). Antimicrobial Properties of Carboxymethyl Cellulose/Starch/N’N Methylenebisacrylamide Membranes Endowed by Ultrasound and Their Potential Application in Antimicrobial Packaging. Polymers, 16(9), 1282. https://doi.org/10.3390/polym16091282
